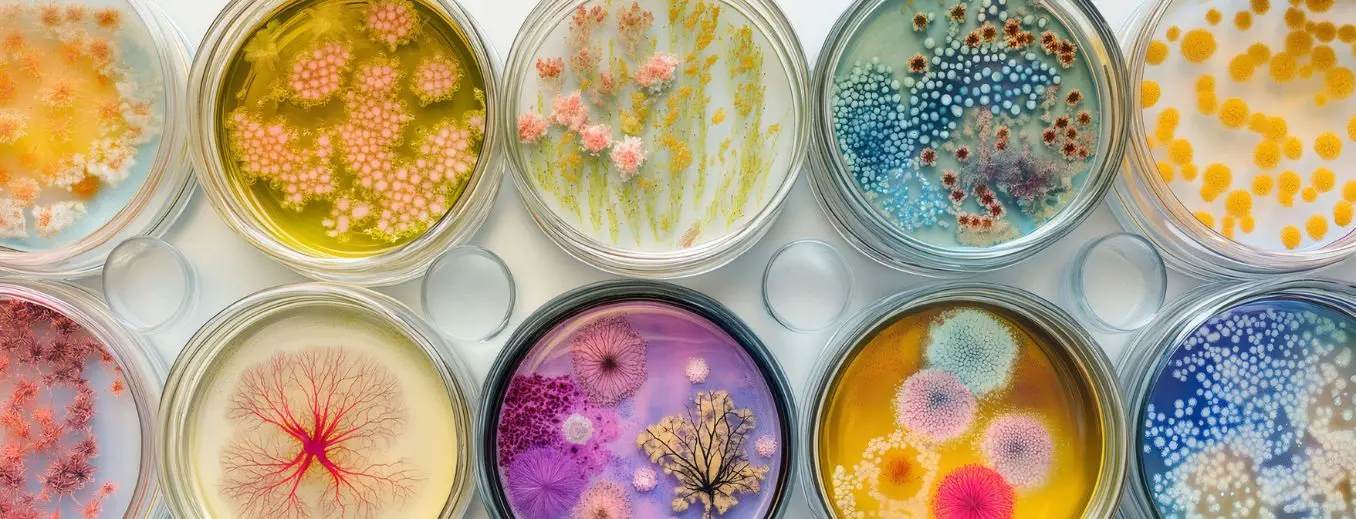

המעבדה לנגיפים וביולוגיה מולקולארית מהווה חלק אינטגראלי מהפעילות השוטפת של מכון האיידס של בית החולים ועוסקת בעיקר באבחון וניטור של חולי HIV.
המעבדה הזו היא הגדולה ביותר בארץ לסקר של נשאים ל-HIV, ומבוצעות בה כשליש מכלל הבדיקות בארץ בתחום הזה. כמו כן, היא אחת מבין שתי המעבדות היחידות בארץ לאבחון מולקולארי של עמידות נגיף האיידס (HIV) לתרופות.
למעבדה מומחיות גבוהה במיוחד, בפיתוח ויישום של בדיקות מולקולאריות לאבחון של מחלות זיהומיות.
בדיקות המתבצעות במעבדה
- בדיקה סוקרת בשיטת (Chemiluminescent Microparticle Immunoassay (CMIA בדם של נבדקים, לזיהוי סימולטני של אנטיגן P24 של HIV ונוגדנים כנגד הנגיף, במטרה לאבחן נשאות ל-HIV.
- בדיקה מולקולארית בשיטת Real-time PCR לקביעה כמותית של HIV בדם. הבדיקה מבוצעת כמעקב שיגרתי אחר נשאים ידועים במטרה לקבוע אסטרטגית טיפול.
- בדיקה של תת-אוכלוסיות של לימפוציטים מסוג CD4 ו-CD8 כמדד לכשל חיסוני ובמטרה לקבוע אסטרטגית טיפול. הבדיקה מתבצעת במכשור מדויק ומתקדם הנקרא Fluoresence Activating Cell Sorter) FACS).
- בדיקה מולקולארית לריצוף הגנים Protease ו- Reverse transcriptase של HIV. הבדיקה מבוצעת על גנום של HIV, המבודד מדם של חולים, ומטרתה לזהות מוטציות המקנות עמידות לנגיף לתרופות אנטי וירליות מסוג
Protease Inhibitors) PIs, (Nucleoside Reverse Transcriptase Inhibitors) NRTIs) ו-Non-nucleoside Reverse Transcriptase Inhibitors) NNRTIs). הבדיקה מבוצעת בקרב חולים שנכשלו בטיפול התרופתי וכן בקרב חולים חדשים, בטרם התחלת טיפול. - בדיקה מולקולארית לריצוף הגן Integrase בגנום של HIV, שמבודד מדם של חולים, במטרה לזהות מוטציות המקנות עמידות לנגיף לתרופות מעכבי Integrase.
- בדיקה מולקולארית בשיטת Real-time PCR לגילוי האלל HLA-B*5701 בחולים המועמדים לטיפול בתרופה האנטי וירלית Abacavir